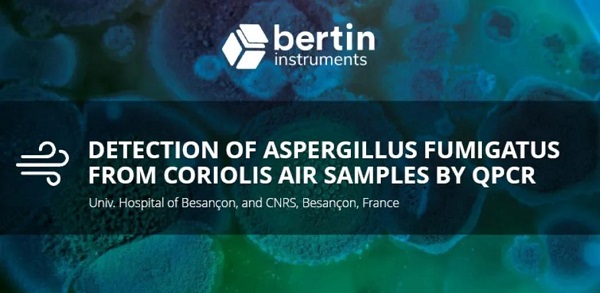

Coriolis:助力医院真菌感染监测

真菌感染在医院是一个持续的威胁,尤其是在血液科和骨髓移植病房住院的高危患者。传统的监测包括将受影响的培养基孵育几天,以便真菌种类可以生长,并根据宏观和微观标准进行鉴定。这些系统因其与培养技术的联系而受到限制,涉及到大约7天的时间间隔和100升/分钟的最大采样率。
本此分享的应用指南旨在结合Coriolis和QPCR技术,评估其在血液科病房和非血液科医院区域2天内检测烟曲霉DNA的效能。
欢迎扫码填表索取!

真菌感染在医院是一个持续的威胁,尤其是在血液科和骨髓移植病房住院的高危患者。传统的监测包括将受影响的培养基孵育几天,以便真菌种类可以生长,并根据宏观和微观标准进行鉴定。这些系统因其与培养技术的联系而受到限制,涉及到大约7天的时间间隔和100升/分钟的最大采样率。
本此分享的应用指南旨在结合Coriolis和QPCR技术,评估其在血液科病房和非血液科医院区域2天内检测烟曲霉DNA的效能。
欢迎扫码填表索取!

